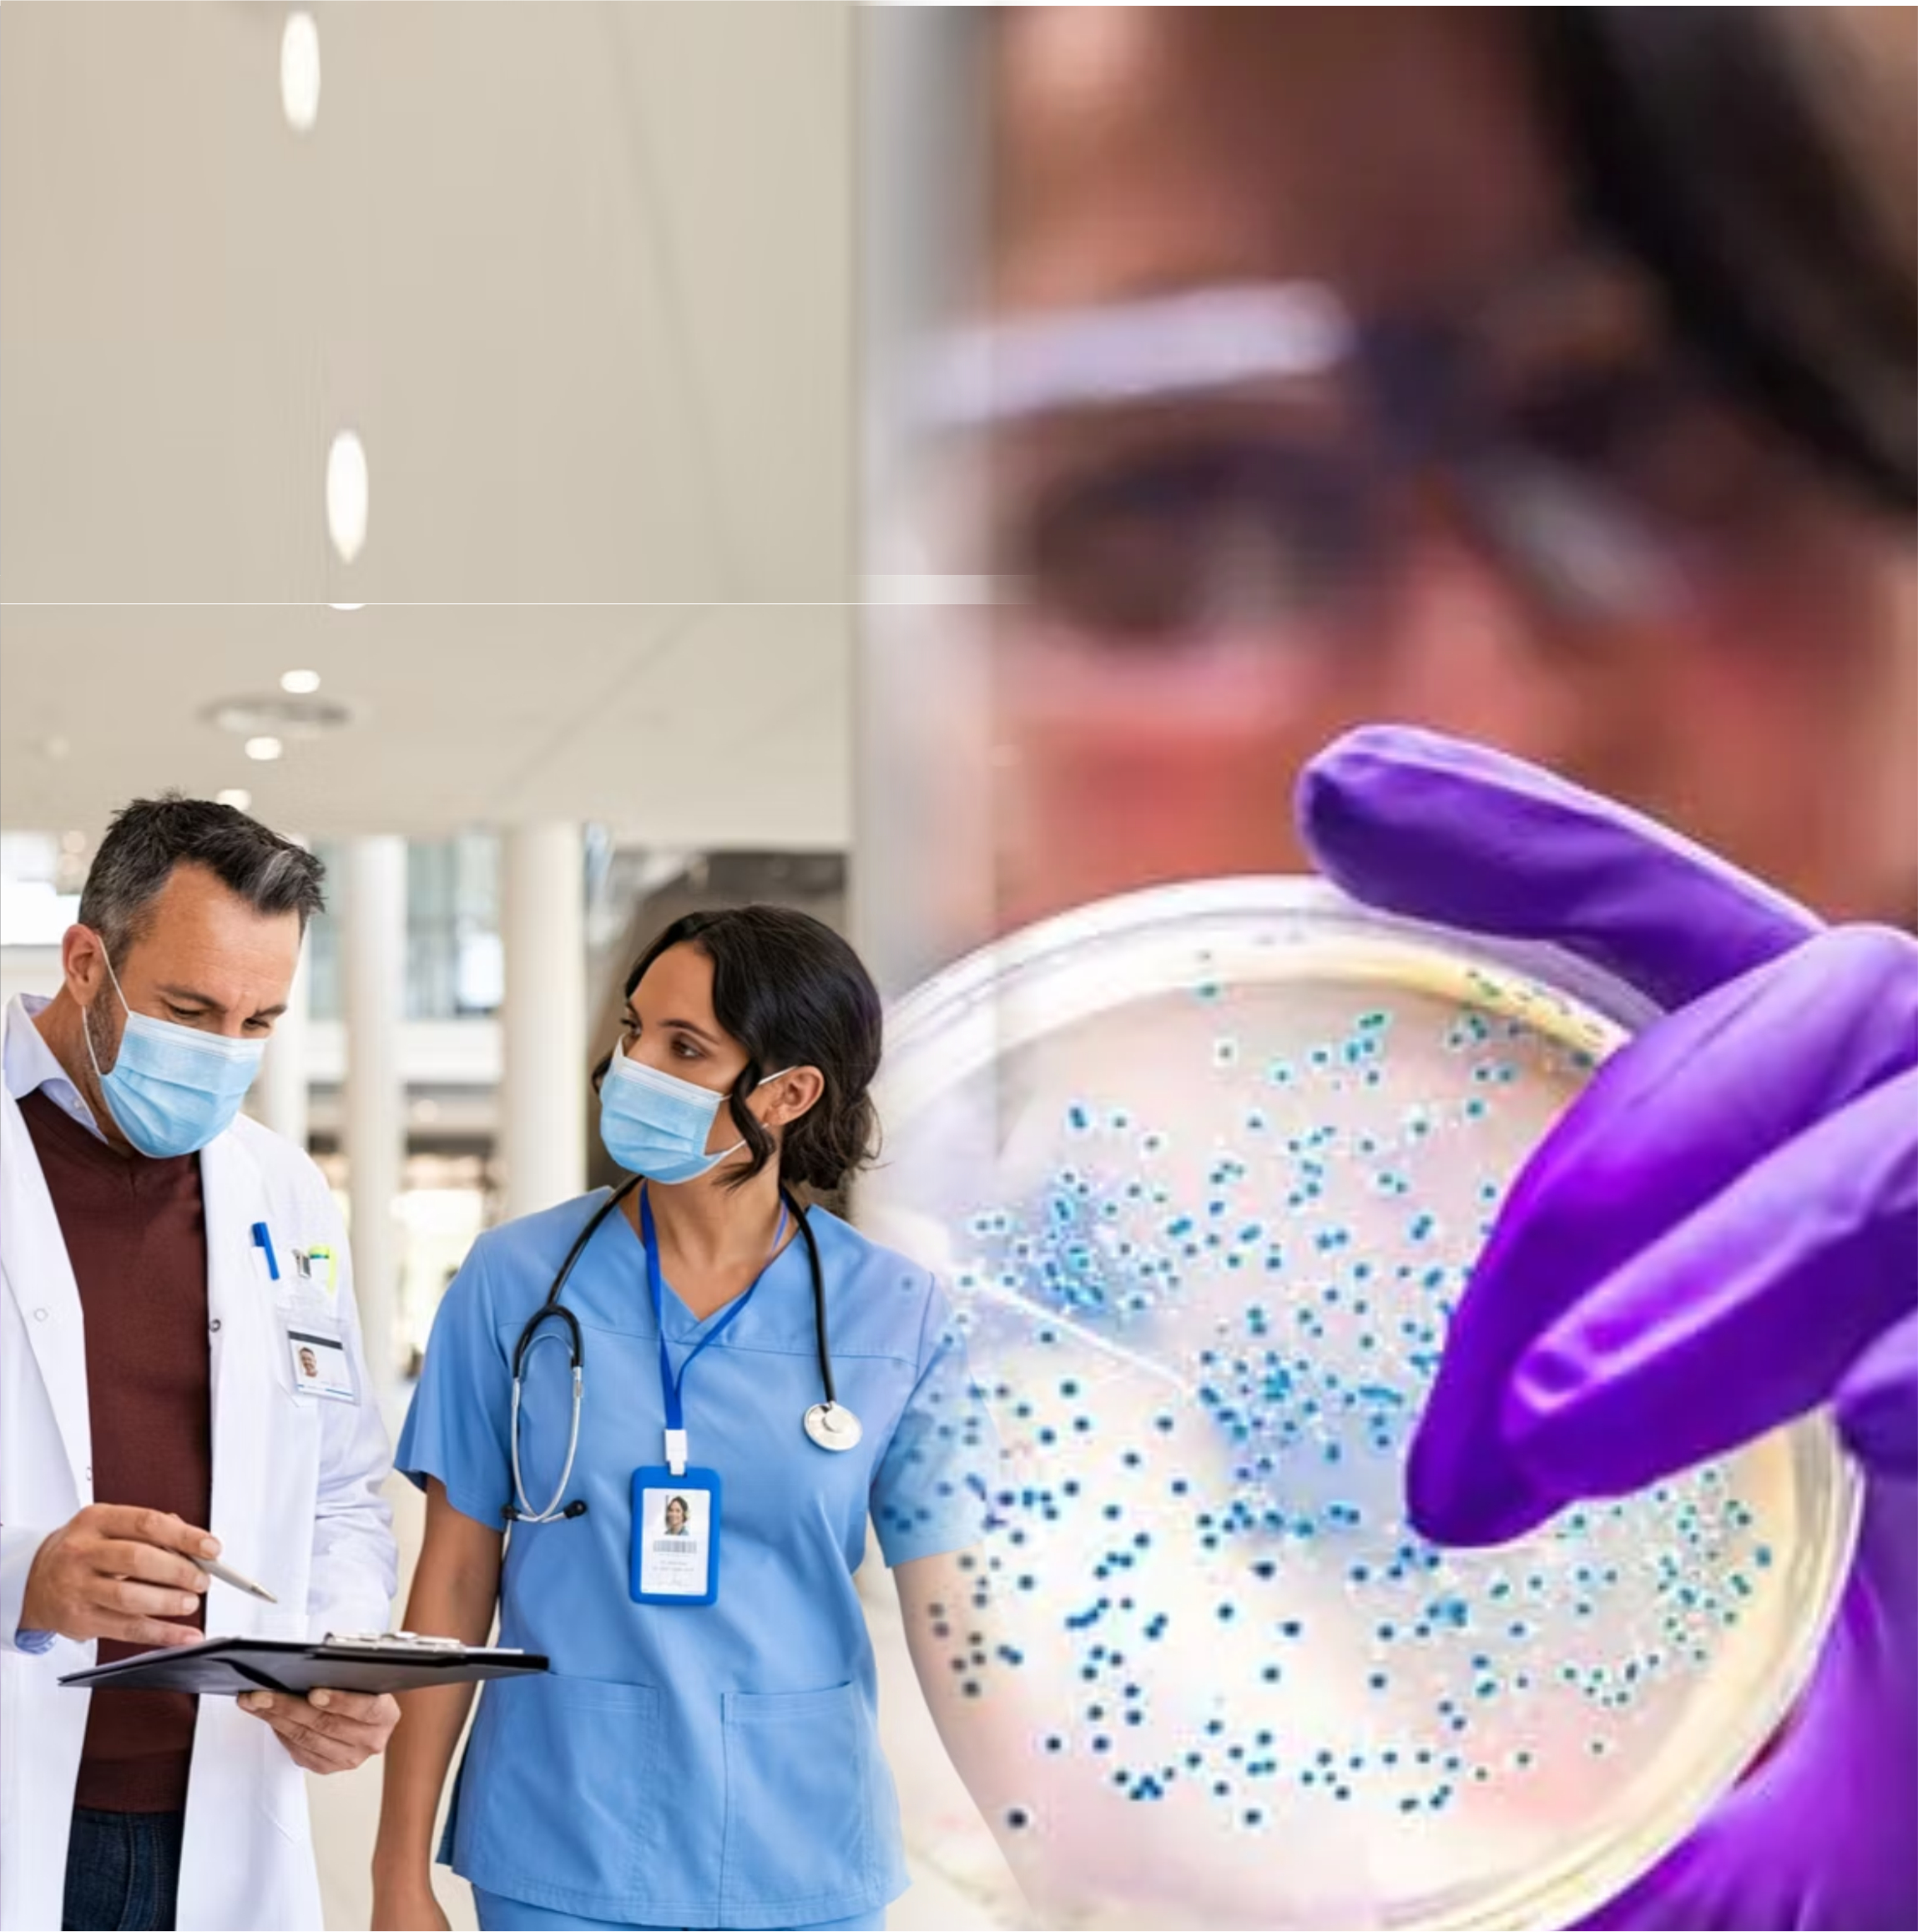

(PREPARATORY COURSE)
PREVENTION & CONTROL (CIC)
and raising awareness
ICC NY, Counsultant
Infection Control.
PREPARE & SUCCEED
CIC PREPARATION MODULE
(PREPARATORY COURSE)
BASED ON APIC BOOK
for
CERTIFICATION IN INFECTION
PREVENTION & CONTROL (CIC)
(PREPARATORY COURSE)
BASED ON APIC BOOK
for
CERTIFICATION IN INFECTION
PREVENTION & CONTROL (CIC)
An initiative For encouraging healthcare
professionals to combat HAI
and make health care facilities safer
professionals to combat HAI
and make health care facilities safer
Why opt for preparation modules?
- Modules are based on APIC book
- Lectures by CIC certified faculties
- Tests & assessments based on the book chapters
- Course material for reference


Why Certify?
- Represents commitment to continual improvement of infection prevention and control functions and their contribution to healthcare and patient safety
- Fosters a recognized professional community that helps to reduce infections in healthcare settings
- The only accredited certification in infection prevention and control
Who can attend?
- Completed post-secondary education in a health-related field including but not limited to medicine, nursing, laboratory technology, or public health.
- Direct responsibility for the infection prevention program activities in a healthcare setting
- Work experience, defined as active engagement in infection prevention, determined by a current job description , for compensation, for a minimum of:
- At least one-year full-time employment OR
- Two (2) years part-time employment OR
- Completed 3,000 hours of infection prevention work experience earned during the previous three (3) years
- Providing standardized measurement of current basic knowledge needed for persons practicing infection prevention and control in all healthcare settings.
- Encouraging individual growth and study, thereby promoting professionalism among infection prevention and control professionals.
The APIC Text book
Comprehensive, peer-reviewed infection prevention & control knowledge book. The APIC Text is the most
comprehensive and up-to-date reference for
infection prevention and control (IPC). Written,
edited, and reviewed by more than 200 subject
matter experts, it reflects the latest guidelines,
regulations, and standards of practice.
The APIC Text’s 11 sections and 125 peer-reviewed chapters are broad ranging, covering everything from fundamental principles, microbiology, epidemiology, and surveillance to more specialized topics, including specialty care populations, special pathogens, occupational health, and supportive care. It’s imperative that infection preventionists have access to the best information available to reduce risk. The APIC Text is your reliable source, designed to be a one-stop shop for effective IPC at your facility
The APIC Text’s 11 sections and 125 peer-reviewed chapters are broad ranging, covering everything from fundamental principles, microbiology, epidemiology, and surveillance to more specialized topics, including specialty care populations, special pathogens, occupational health, and supportive care. It’s imperative that infection preventionists have access to the best information available to reduce risk. The APIC Text is your reliable source, designed to be a one-stop shop for effective IPC at your facility

Benefits of APIC Text Book
Authoritative – Peer-reviewed, fully referenced, and written by experts in IPC
Up To Date – The APIC Text is responsive to changes in the field, updated as standards and regulations change
Testimonials







Our Pride














